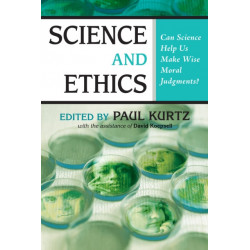
Science and Ethics: Can Science Help Us Make Wise Moral Judgments?

Ingen varer
Prometheus Books Forlag
Visning: Type : Alle | Sprog : Alle | Format : Alle
-
Bemærk: Kan ikke leveres før jul.
Electoral Bait and Switch: How the Electoral College Hurts American Voters and What Can Be Done about It (Bog, Paperback / softback, Engelsk)Electoral Bait & Switch is prescriptive, and accessible to the general reader. If it is not... Læs mere
Levering: Skaffevare (forvent 14 - 30 hverdage) -
Bemærk: Kan ikke leveres før jul.
The Crisis (Bog, Paperback / softback, Engelsk)In the winter of 1776, the American War of Independence was in trouble. Thomas Paine, who had previously inspired the revolutionary cause with his pamphlet "Common Sense", published the essays... Læs mere
Levering: Skaffevare (forvent 14 - 30 hverdage) -
Bemærk: Kan leveres før jul.
Guilt, Shame, and Anxiety: Understanding and Overcoming Negative Emotions (Bog, Paperback / softback, Engelsk)Levering: 6 - 9 hverdage -
Bemærk: Kan ikke leveres før jul.
On Liberty (Bog, Paperback / softback, Engelsk)In the history of political philosophy, great minds have sought to define the nature and extent of human freedom, with justifications offered for the principles proposed. This title defends individual liberty against both social and political encroachment.
Levering: Skaffevare (forvent 14 - 30 hverdage) -
Bemærk: Kan ikke leveres før jul.
Navigating the Mindfield: A Guide to Separating Science from Pseudoscience in Mental Health (Bog, Paperback / softback, Engelsk)Brings together non-technical articles by leading scientific researchers and clinicians to help answer questions... Læs mere
Levering: Skaffevare (forvent 14 - 30 hverdage) -
Bemærk: Kan leveres før jul.
Rocket Age: The Race to the Moon and What It Took to Get There (Bog, Hardback, Engelsk)Levering: 6 - 9 hverdage -
Bemærk: Kan ikke leveres før jul.
The Placebo Effect And Health: Combining Science & Compassionate Care (Bog, Paperback / softback, Engelsk)As medical technology and treatment have improved, and time constraints have become more demanding, the beneficial effects of meaningful... Læs mere
Levering: Skaffevare (forvent 14 - 30 hverdage) -
Bemærk: Kan ikke leveres før jul.
Science and Ethics: Can Science Help Us Make Wise Moral Judgments? (Bog, Paperback / softback, Engelsk)Maintains that science can help us make wise choices and that an increase in scientific knowledge can help modify our ethical values and... Læs mere
Levering: Skaffevare (forvent 14 - 30 hverdage) -
Bemærk: Kan ikke leveres før jul.
Washington's Engineer: Louis Duportail and the Creation of an Army Corps (Bog, Hardback, Engelsk)Levering: Skaffevare (forvent 14 - 30 hverdage) -
Bemærk: Kan ikke leveres før jul.
The Accessible Hegel (Bog, Paperback / softback, Engelsk)Georg Wilhelm Friedrich Hegel was one of the most influential philosophers of the 19th century. There is a good deal of debate about exactly how to interpret his words. For both... Læs mere
Levering: Print on Demand (forvent 14 - 30 hverdage) -
Bemærk: Kan ikke leveres før jul.
Contemporary Analytic and Linguistic Philosophies (Bog, Paperback / softback, Engelsk)Offers an introduction to several aspects of one of the most influential schools of thought in the twentieth century. This work begins by pointing out... Læs mere
Levering: Skaffevare (forvent 14 - 30 hverdage) -
Bemærk: Kan ikke leveres før jul.
The Ethics of Organ Transplants (Bog, Paperback / softback, Engelsk)Advances in medical technology and science have made organ procurement, or the search and transfer of organs and tissue from one body to another, an important issue. How... Læs mere
Levering: Skaffevare (forvent 14 - 30 hverdage)